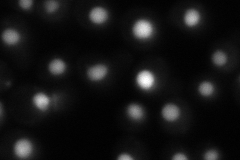
YER030W
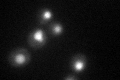
YER030W

View description
Histone chaperone for Htz1p/H2A-H2B dimer; required for the stabilization of the Chz1p-Htz1-H2B complex; has overlapping function with Nap1p; null mutant displays weak sensitivity to MMS and benomyl; contains a highly conserved CHZ motif
Localization:
Intensity:
Fold change:
Significance:
-
C’ GFP library in SD

nucleus50.33 -
N' NOP1pr-GFP in SD

nucleus247.866 -
N' TEF2pr-mCherry in SD

nucleus336.106 -
N' NATIVEpr-GFP in SD
nucleus81.3431 -
N' TEF2pr-VC and Cyto-VN in SD

nucleus74.7727 -
C’ GFP library in SD+DTT

nucleus49.710.98No -
C’ GFP library in SD+H2O2
nucleus46.840.93No -
C’ GFP library in Starvation Media

nucleus61.511.22No -
C’ GFP library on the background of Pup2-DaMP

nucleus -
C’ GFP library on the background of CCT mutant

nucleus46.57090.925206No
